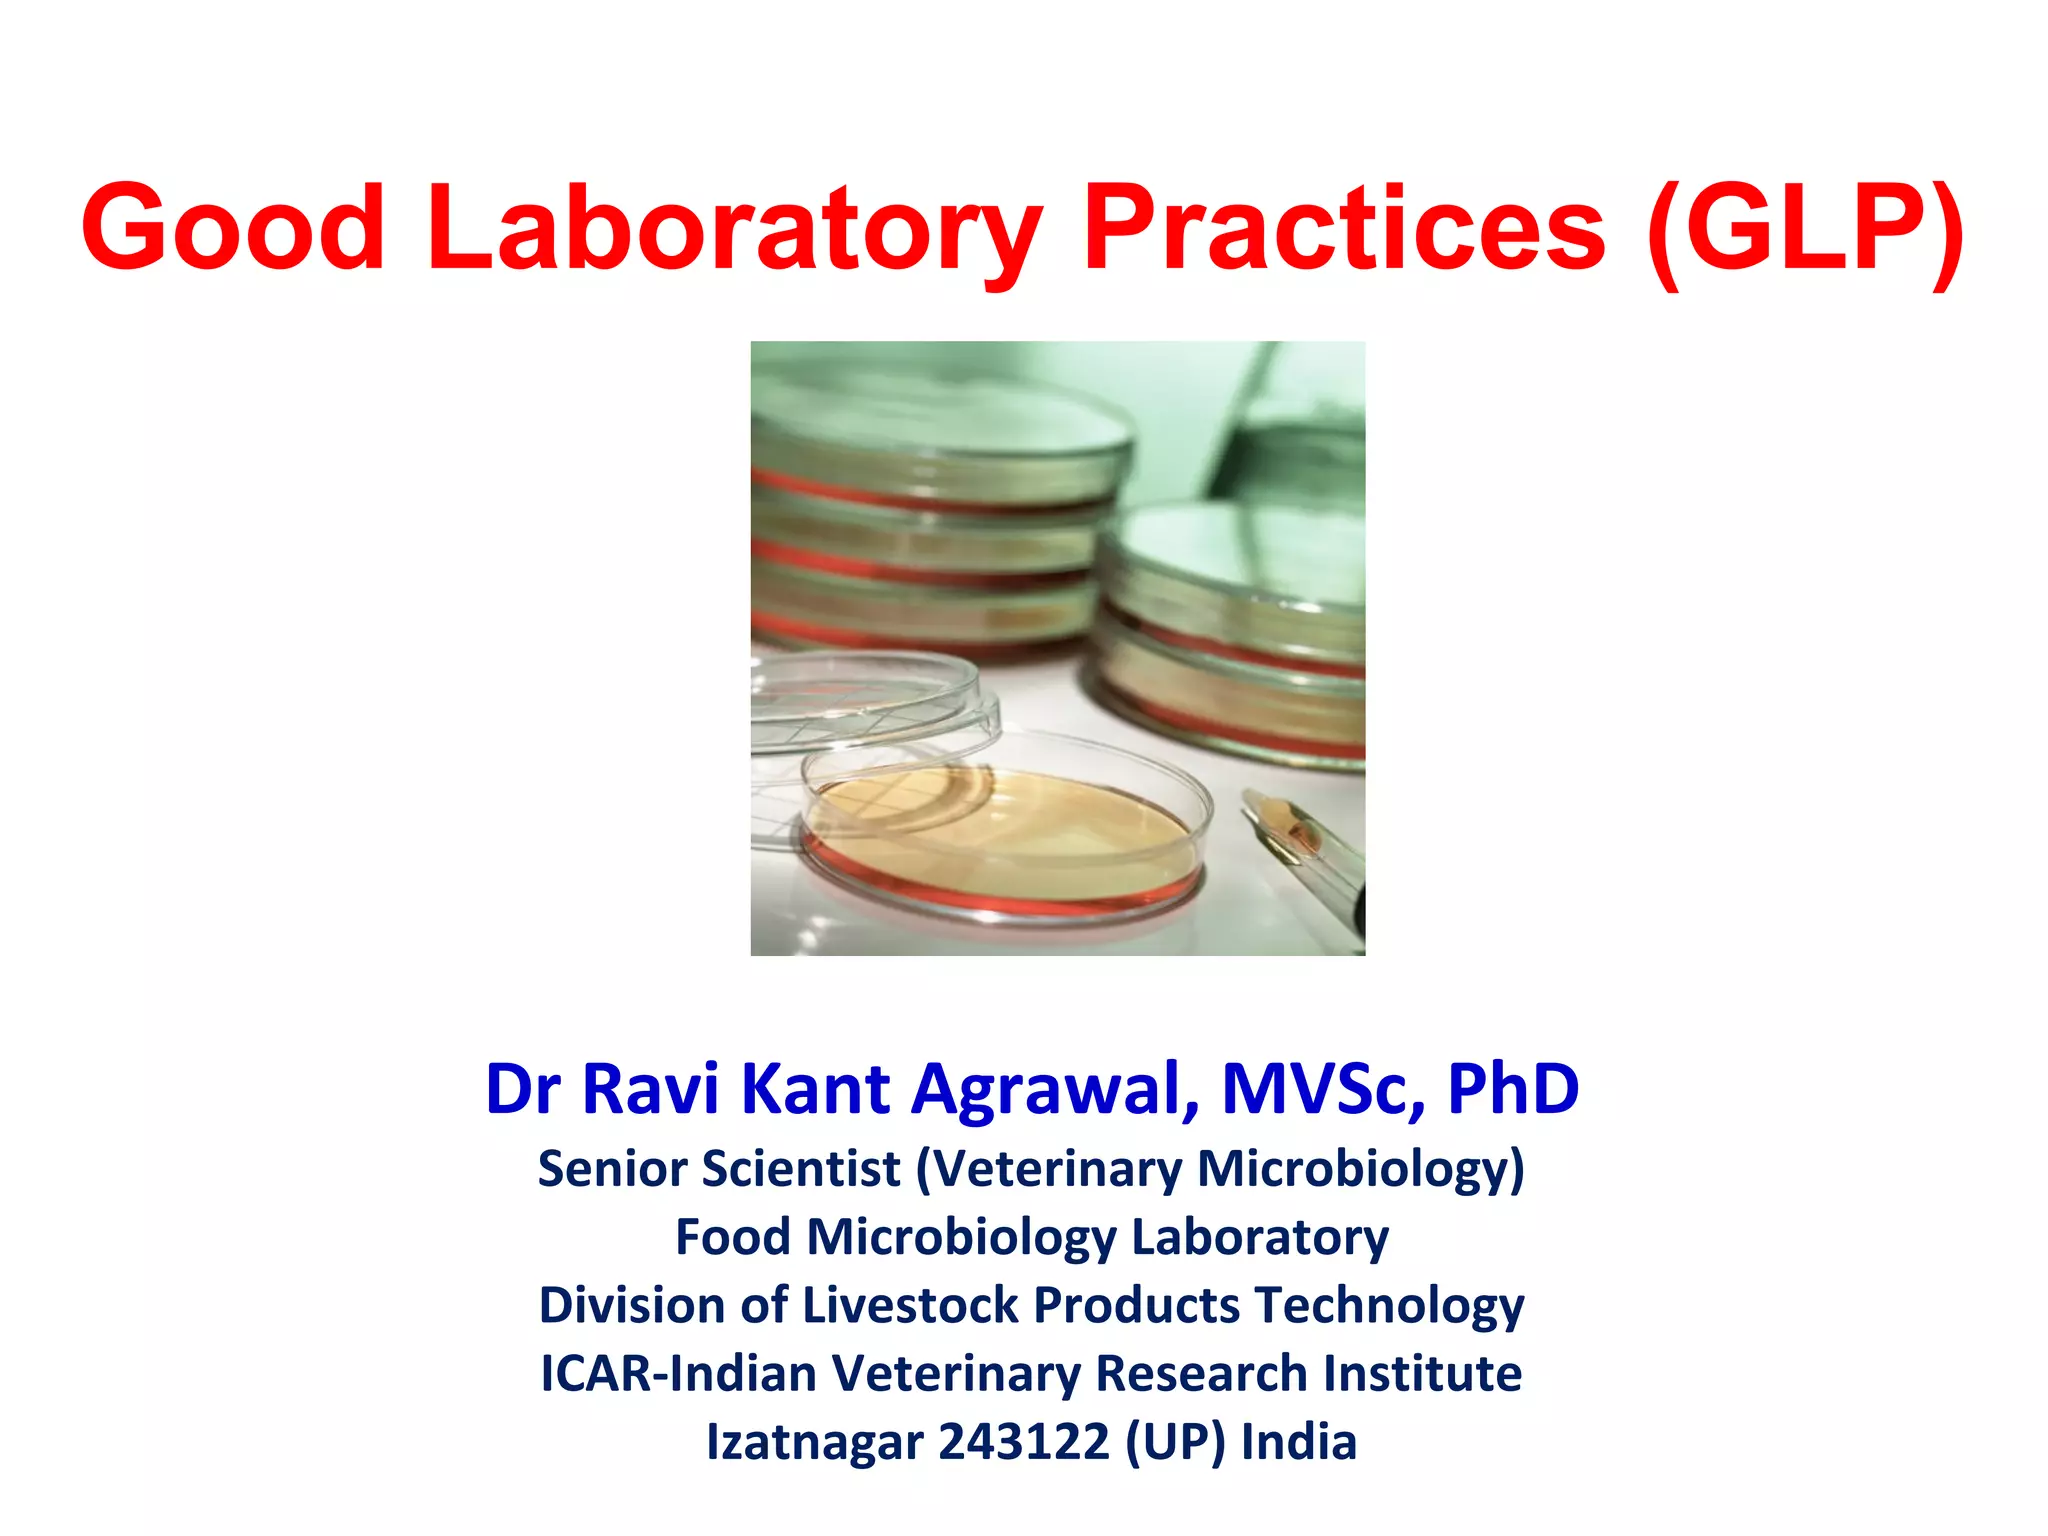

The document discusses Good Laboratory Practices (GLP). It provides definitions and history of GLP. GLP refers to a quality management system for laboratories conducting non-clinical safety studies. It aims to ensure reliability and integrity of test data. Key aspects of GLP include organization, SOPs, facilities, equipment, test systems, study planning and reporting, archiving. Non-compliance can result in disqualification and rejection of study data by regulatory agencies.

![HISTORY
• In 1981 an organization named OECD (Organization for
Economic Co-operation and Development) produced GLP
principles that are international standard.
• OECD has since helped promulgate GLP to many countries.
• Following Decision C(97),186/Final of the OECD Council, data
generated in the testing of chemicals in one OECD Member
Country, in accordance with OECD Test Guidelines and the
Principles of GLP are accepted in all other OECD Member
Countries. OECD: ENV/MC/CHEM(98)17 part two
• GLP is a quality system concerned with the organizational
process and conditions under which non-clinical health and
environmental safety studies are planned, performed,
monitored, recorded, archived and reported.[5]](https://image.slidesharecdn.com/goodlabpracticesglp-181210114607/85/Good-lab-practices-GLP-5-320.jpg)


























